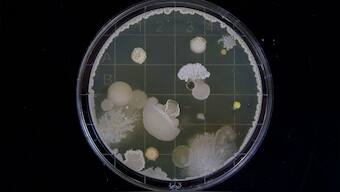

Researchers have identified over 6,000 antibiotic resistance genes found in bacteria that inhabit the human gut, which is home to trillions of micro-organisms, mainly
bacteria
. “Most gut bacteria live in a harmless relationship with the human host. However, the gut is also home to bacteria that can cause infections in hospitalised patients,” said one of the researchers Willem van Schaik, Professor at the University of Birmingham. “Unfortunately, these bacteria are becoming increasingly resistant to
antibiotics
and we need to understand the processes that contribute to this development,” he added. [caption id=“attachment_5532011” align=“alignnone” width=“1280”]
Representational Image[/caption] To identify resistance genes in gut bacteria, team of researchers, led by the Institut National de la Recherche Agronomique (INRA) in France, developed a new method by comparing the three-dimensional structures of known antibiotic resistance enzymes to the proteins that are produced by gut bacteria. They then applied this method to a catalogue of several million genes of the gut, leading to the identification of over 6,000 antibiotic resistance genes that are very different from previously identified genes in pathogenic bacteria, according to the study published in the journal Nature Microbiology. “Most of these genes appeared to be present in bacteria that live in a harmless relationship with the human host, so may not be an immediate threat to human health,” van Schaik said. “However, the continuing use of antibiotics may lead to these resistance genes being transferred to pathogenic bacteria, thereby further reducing the effectiveness of antibiotics in treating infections,” he added.
)